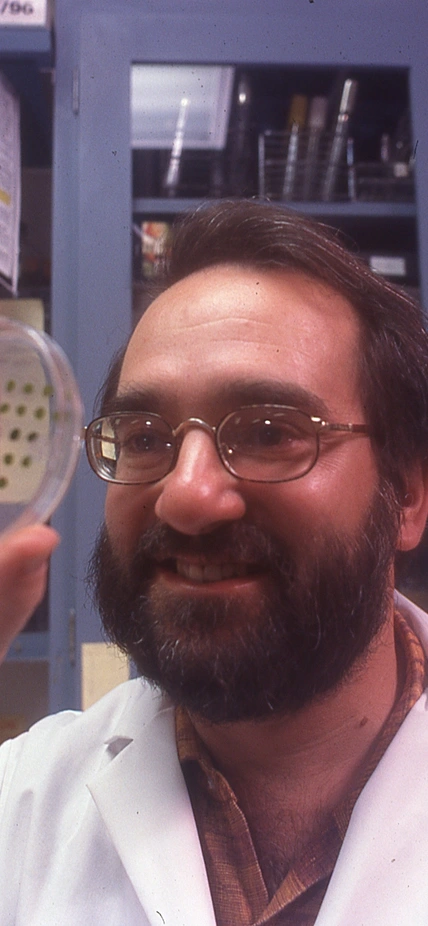
Arthur Grossman with a petri dish

2024 Year Book
The 2024 Year Book reflects this continuum of discovery, highlighting the scientists driving today’s breakthroughs, honoring the legacies that shaped entire fields, and revealing the instruments and ideas guiding what comes next.

We are scientists, yes, but also historians, storytellers, philosophers, and visionaries.
Message from Our President
When I introduce myself and Carnegie Science to new friends and neighbors, the conversation typically, and quickly, moves toward talking about the future: new postdocs, cascading breakthroughs, innovations in instrumentation. I understand the impulse. Our mission is to advance humankind, and every leap forward in society has been powered by science and technology.
But the nature of our research—seeking to understand who we are and how we got here—requires us to also keep one foot in the past and a firm grasp on the present. We are scientists, yes, but also historians, storytellers, philosophers, and visionaries. From genomes to ecosystems, moments to millennia, we are masters of scale. This holistic approach, entwined with our spirit of transformational discovery, is a defining feature of Carnegie Science. For 123 years, this strength has fueled discoveries that continue to shape the world. And it’s alive and well today.
At the Earth and Planets Laboratory, where generations have explored our planet’s geologic history and the mysteries of worlds beyond our own, a new cohort of scientists, like geochronologist Jennifer Kasbohm and isotope geochemist Andrea Giuliani, are using advanced tools to explore enduring questions that remain: where did we come from, and how can ancient building blocks inform a more sustainable future?
Understanding life and the minute-by-minute processes that sustain it is key to answering those questions. Carnegie biologist Arthur Grossman, a staff scientist for more than four decades, was recently elected to the National Academy of Sciences for his pioneering work in photosynthesis. Arthur’s multidisciplinary approach is an inspiration for the next generation of Carnegie scientists, and a testament to the flexibility and creativity at the heart of our institutional model.
Meanwhile, our astronomers at the Carnegie Science Observatories are joining those at EPL in reaching ever deeper into the expanding universe with next-generation instruments and telescopes. From revealing the composition of exoplanet atmospheres to illuminating the first stars and galaxies, they are building a stronger foundation of knowledge about the universe and our place within it.
Of course, instruments are only as powerful as the people behind them. Our reputation for bold research—past, present, and future—is rooted in the brilliance and dedication of individual researchers and leaders. This year, we lost two such giants: former Carnegie Science President Maxine Singer and trailblazing cell biologist Joseph Gall. Their scientific achievements were matched only by their unwavering commitment to mentoring others and nurturing new generations of scientific talent.
I invite you to explore and celebrate another year of excellence at Carnegie Science. Learn about the people at the heart of our work. Commemorate milestones like the 20th anniversary of the MESSENGER mission. Discover the advancements in instrumentation across our campuses. And join us now in recognizing those supporters whose generosity is propelling us into the future.
Thank you for being a part of Carnegie Science’s past, present, and future.
Sincerely,
John Mulchaey
President, Carnegie Science

Celebrating a Legacy
From revealing a universe beyond our galaxy to exploring the innermost planet and uncovering the unseen forces that shape the cosmos, Carnegie Science’s legacy is woven into the discoveries that continue to shape our understanding of the universe.

Celebrating Hubble Discovery Centennial | 
Marking 20 Years Since MESSENGER |

Vera Rubin's Legacy Inspires Community Art Project | 
Maxine Singer and Joseph Gall Remembered |

Transforming Science Today
From eclipse-day outreach to new scientific voices at the Earth and Planets Laboratory, Carnegie Science is advancing discovery through bold ideas, collaborative research, and scientists who are shaping the present—and the future.

Emily Zakem’s Bold Exploration Beneath the Surface | 
Putting Astronomy into Action at Great North American Eclipse |
Arthur Grossman’s Visionary Science Honored | 
New Staff Scientists Bring Bold Vision to Earth and Planets Laboratory |

The Future of Discovery
By investing in next-generation tools and the people who power discovery, Carnegie Science is building the foundation for breakthroughs still to come—advancing bold ideas and shaping the future of science together.

New Tools Expand EPL’s Research Capabilities | 
Instrumentation Keeps Carnegie Astronomers at the Cutting Edge | |

Carnegie Champions: Together We Can Shape the Future of Science |

